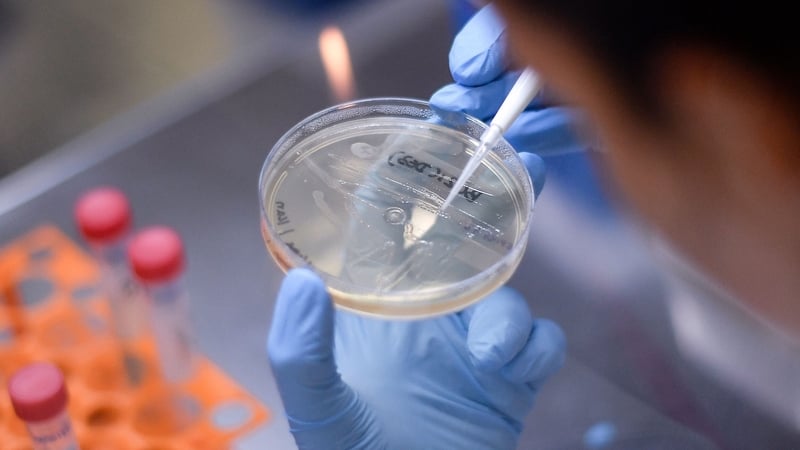
The company develops oncology drugs with a focus on rare, orphan and pediatric cancers

Irish pharma startup Shorla has raised $8.3m in new funding.
The Series A round was led by Dublin based venture capital fund, Seroba Life Sciences.
Enterprise Ireland also took part in the funding round.
The money will be used by the two year old firm to advance a number of its oncology products to the US market and support its pipeline.
The company develops oncology drugs with a focus on rare, orphan and pediatric cancers and claims it has a strong pipeline of innovative new drugs.
It was founded by Sharon Cunningham and Orlaith Ryan, both former workers with EirGen Pharma in Waterford.
The company is based in Questum, an acceleration centre in Clonmel.